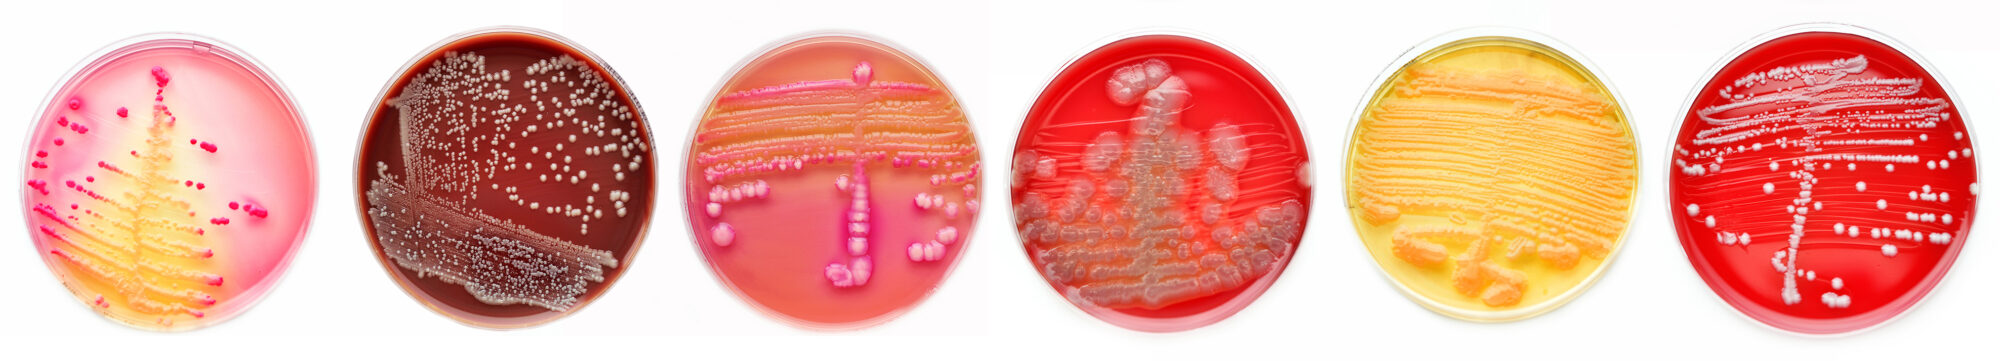

L’intérêt pour les solutions économiques n’a jamais été aussi fort, tant dans la vie personnelle que professionnelle. De plus en plus, chacun cherche à optimiser les dépenses, que ce soit à la maison ou au travail. Les entreprises et industries, partout dans le monde, privilégient des approches innovantes et pratiques qui favorisent l’efficacité, la productivité et la croissance.
À travers le monde, dans les laboratoires spécialisés en microbiologie, certains maintiennent leurs propres stocks de cultures, une méthode qu’ils jugent plus rentable.
En réalité, cela peut coûter le même prix, ou même moins cher, d’acheter des souches de contrôle de qualité prêtes à l’emploi. Ces dernières ont démontré leurs capacités, via des critères internationaux et la participation à l’accréditation des laboratoires. Cela vous donne l’assurance que les produits sont de la plus haute qualité.
Acheter des consommables de laboratoire prêts à l’emploi pourrait ainsi offrir des résultats plus cohérents, ce qui permet le respect des règles, tout en assurant au laboratoire de suivre les meilleures pratiques.
Une analyse financière approfondie des coûts des cultures stock, en passant par les fournitures et équipements supplémentaires, ou encore le temps passé en laboratoire, pourrait révéler que le coût de maintien des souchiers est égal voire supérieur à l’achat de souches de contrôle de qualité prêtes à l’emploi.
L’analyse des coûts d’une souchotèque
Il existe de nombreuses solutions pour se procurer des souches, sous tous les formats et à tous les prix.
Pour vous assurer que les produits sont adaptés, il faut rechercher toutes les options possibles. Analyser les prix de chaque fournisseur ainsi que les produits proposés. Il faut considérer les types de test à effectuer et toutes les exigences liées aux souches microbiologiques.
<< Par exemple, a-t-on besoin d’une concentration spécifique ? Allez-vous investir beaucoup de temps et de fournitures pour atteindre cette valeur ? >>
Il sera plus économique d’acheter des produits prêts à l’emploi, qui vous donneront la concentration désirée avec un temps de préparation minimum, évitant donc de dépenser beaucoup de temps et d’argent pour créer une souche de travail qui répondra à vos besoins.
Préserver votre souchotèque
La lyophilisation est une méthode largement reconnue pour conserver les microorganismes sur le long terme, offrant de bons résultats de stabilité. Lorsqu’on choisit une solution en interne, il est nécessaire de s’équiper d’un matériel adapté et performant, ainsi que de former les équipes pour une utilisation optimale : ces investissements témoignent du sérieux de la démarche, mais peuvent représenter un coût non négligeable pour un laboratoire de taille modeste.
C’est pourquoi s’appuyer sur le savoir-faire de professionnels comme Microbiologics pour la lyophilisation est souvent une alternative rentable, qui libère du temps et permet de se concentrer sur le cœur d’activité.
Une autre option, c’est la cryoconservation : on garde les microorganismes à très basse température, sous zéro. Mais là encore, il faut investir dans un liquide spécial pour les protéger et surtout dans un congélateur ultra-puissant qui descend à -70 °C ou moins. Ce genre d’équipement représente un investissement important pour le laboratoirerepiquages et nécessite un entretien pointilleux.
Si le laboratoire n’a pas le budget pour ce genre de matériel, le plus simple peut être d’acheter des cultures prêtes à l’emploi, déjà stables, faciles à manipuler, et qui se conservent au réfrigérateur. C’est une solution à la fois pratique et économique.
Le temps de travail
Quand on choisit de gérer ses propres cultures de microorganismes, il est essentiel de prendre en compte le savoir-faire et l’implication de l’équipe. La préparation, le repiquage, l’étiquetage, la conservation, ainsi que le nettoyage et l’entretien du matériel sont des étapes minutieuses qui mobilisent les compétences des techniciens.
Il est judicieux d’optimiser l’organisation pour permettre à l’équipe de se concentrer sur des tâches à forte valeur ajoutée, participant ainsi au développement et à la performance du laboratoire. On oublie souvent que le salaire des employés est l’une des plus grosses dépenses d’un laboratoire, et il doit être pris en compte quand on évalue le vrai coût de ce genre de processus.

La plus grande souchotèque du monde :
Nombre de passage
Tous les microbiologistes vous le diront : les bactéries se reproduisent rapidement. Mais chaque fois qu’on les replante (ce qu’on appelle un repiquage), il y a un risque qu’elles changent, que ce soit au niveau de leur ADN ou de leur comportement. Et plus on les repique, plus le risque de mutation augmente.
Alors pourquoi prendre le risque d’utiliser des souches qui ont changé au fil du temps, quand on peut simplement acheter des souches prêtes à l’emploi, limitées à 4 repiquages maximum, directement issues d’une culture de référence fiable ?
Les conditions de stockage
Selon la méthode de stockage, les microorganismes peuvent changer. Si les conditions de conservation ne sont pas bonnes, ils peuvent s’adapter à leur nouvel environnement et subir des mutations (des changements génétiques).
Ces mutations peuvent fausser les résultats des tests, par exemple en rendant une bactérie méconnaissable ou en modifiant sa réaction aux antibiotiques. Parfois, les microorganismes peuvent même mourir ou ne plus être utilisables.
En revanche, les souches prêtes à l’emploi sont spécialement préparées pour se conserver durablement sans altération, garantissant ainsi leur fiabilité.

La vérification
Quand un labo garde ses propres cultures, il faut régulièrement vérifier que la méthode de conservation fonctionne bien et que les microorganismes sont toujours vivants et stables. Comme chaque type de bactérie réagit différemment au stockage, il faut tester chaque souche pour s’en assurer.
En comparaison, les souches prêtes à l’emploi sont déjà testées, emballées dans des formats pratiques et affichent une date de péremption claire. Pas besoin de se poser de questions : elles sont garanties stables et utilisables jusqu’à cette date.
Audits et traçabilité
Tout le monde sait que la traçabilité, c’est essentiel. Quand un auditeur demande des documents précis, c’est vite stressant si on ne les trouve pas. Si on garde ses propres cultures au labo, il faut absolument archiver tous les papiers nécessaires, à la fois pour bien s’organiser et pour être prêt en cas de contrôle.
Mais quand on a beaucoup de souches à gérer, ça peut devenir complexe et chronophage de tout suivre correctement.
À l’inverse, les microorganismes prêts à l’emploi sont fournis avec tous les documents nécessaires (tests, traçabilité, certificats…), ce qui garantit une gestion plus simple et sécurisée.
Des procédures fiables
Que vous soyez client ou fabricant, la sécurité et la qualité des produits sont essentielles pour la réussite de votre entreprise. S’appuyer sur des procédures rigoureuses permet d’assurer la continuité des ventes, de renforcer la confiance des clients et de préserver une excellente réputation, bénéfique pour toute l’équipe et la marque.
Opter pour des souches prêtes à l’emploi, plutôt que de gérer ses cultures en interne, peut offrir des économies insoupçonnées et une véritable tranquillité d’esprit : en intégrant tous les coûts, vous verrez souvent que cette solution se révèle aussi avantageuse, voire supérieure.
Alliance Bio Expertise, partenaire de Microbiologics, met à votre disposition des souches de qualité, dans des formats simples et pratiques qui simplifient votre quotidien. Vous bénéficiez d’une garantie de fiabilité, d’identification et de pureté, tout en optimisant vos ressources et votre temps.
LES SOUCHES MICROBIOLOGICS EN VIDÉO
👉 Vous souhaitez en savoir plus sur les souches microbiologics ? Contactez-nous dès maintenant :
Contact :
« * » indique les champs nécessaires





